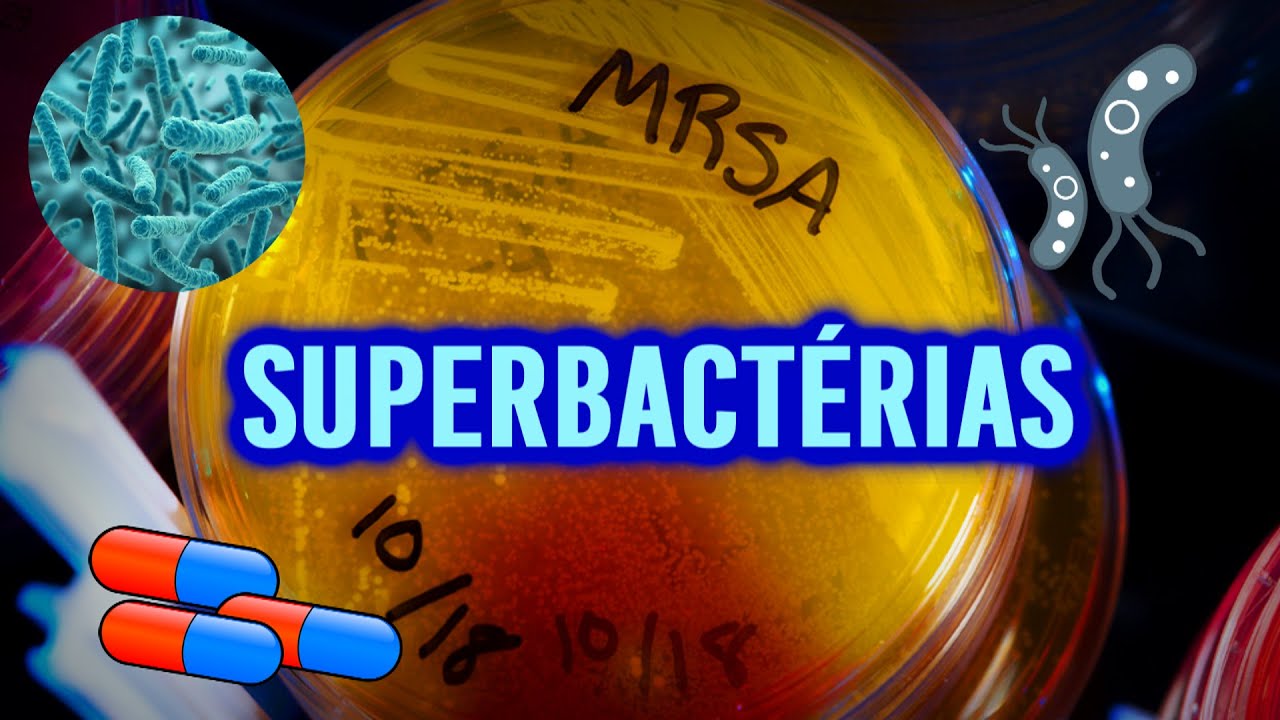
O que são superbactérias?

as pílulas existência Marcelo dividir essa luz câmera e ciências sobre resistência antimicrobiana no episódio de hoje vamos conversar sobre o que é a resistência antimicrobiana e por que ela é importante a Organização Mundial da Saúde OMS define a existência antimicrobiana como a capacidade de um micro-organismo impedir a atuação de um antimicrobiano apesar de as mutações que geram resistência serem um fenômeno natural uso indiscriminado de antibióticos antifúngicos e antivirais é um fator que potencializa esse processo o problema afeta principalmente bactérias mas também é visto em vírus parasitas e fungos patógenos existentes se tornam cada vez mais
difíceis de tratar exigindo doses mais elevadas ou a troca do princípio ativo no medicamento que pode ser mais caro com mais efeitos colaterais ou ainda não disponível um exemplo extremo disso são as superbactérias como o kbcs BL entre outras elas são bactérias resistentes a múltiplos anti-microbianos também chamado de rnm resistentes a múltiplos medicamentos ou MDR do inglês retirar gorduras trans e que por isso são ainda mais complexas de Natal mas como acontece a resistência antimicrobiana teremos um vídeo dedicado apenas aos mecanismos de resistência mas de forma geral o desenvolvimento dela se dá principalmente pelo uso
indevido desses fármacos na medicina humana e veterinária e na odontologia a circulação desses patógenos existentes pode acontecer entre humanos e animais ou por meio da comida da água e do ambiente E além disso a transmissão pode ser favorecida pelo comércio viagens e pelas migrações tanto humanos como animais é mas porque esse assunto é importante Como dito anteriormente patógenos existentes não são tratáveis pelos fármacos comuns e por isso as infecções se tornam persistentes e até incuráveis podem levar à morte é mais frequentemente profissionais da saúde tem dos Remédios considerados como último recurso e como comentamos normalmente
são mais caros e causam mais efeitos colaterais alguns casos de tuberculose e gonorreia são resistentes até aos antibióticos de último recurso ainda cirurgia de rotina e quimioterapia para câncer além de outras condições que levam à imunossupressão para se tornar menos segura sem antibióticos capazes de proteger contra eventuais infecções atualmente a OMS estima que 700 mil mortes sejam causadas pela resistência aos antimicrobianos todo ano de acordo com o economista britânico de ironia até 2050 10 milhões de óbitos serão atribuídas a resistência antimicrobiana todo ano mas o que o câncer mata atualmente 9,6 milhões segundo o instituto
nacional do Câncer Neste contexto o impacto da perda de produtividade na economia Global será de 100 milhões de dólares e ainda o prolongamento das internações hospitalares EA elevação dos custos dos tratamentos afetaram é considerável o sistema de saúde e o que fazer para impedir que isso tudo aconteça a OMS criou um plano de ação global para combater a resistência antimicrobiana em que foi adotado a estratégia de saúde única a intersecção entre a saúde humana a saúde animal e o meio ambiente contando com a colaboração interdisciplinar entre as áreas do conhecimento considerando que os antimicrobianos são
importantes para a medicina tanto humana quanto animal e também são usados na produção de alimentos é importante que todos esses setores colaborem onde os objetivos do plano é o incentivo à pesquisa de novas opções farmacológicas é o primeiro antibiótico foi a penicilina que revolucionou a medicina em 1928 nos anos seguintes a produção continuam relevantes até atingir seu ápice na década de 1950 e 60 chamadas de era de ouro em que foram descobertas 14 novas classes Porém desde 1987 até hoje não houve nenhuma nova classe de antibióticos para compensar o surgimento de cepas resistentes por isso
o investimento na busca de novos remédios É extremamente importante no próximo vídeo vamos conversar sobre alguns mecanismos bacterianas que permitem a inativação dos antibióticos se inscreva no canal para não perder o E aí